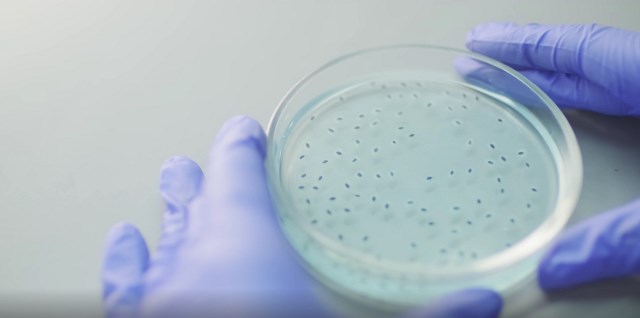

FITNESS & HEALTH
3 Berita Terpopuler Gaya: Daftar Patogen Global Hingga Praktik Mindfulness
Yatin Suleha
Rabu 04 September 2024 / 06:31
Jakarta: Organisasi Kesehatan Dunia (WHO) baru-baru ini memperbarui daftar patogen global yang berpotensi menyebabkan epidemi atau pandemi. Pembaruan yang termaktub dalam dokumen bertajuk “WHO R&D Blueprint for Epidemics: Pathogens Prioritization, A Scientific Framework For Epidemic And Pandemic Research Preparedness” ini telah dipublikasikan pada 30 Juli 2024.
Dokumen tersebut menekankan pentingnya kesiapsiagaan, kolaborasi, dan kerja sama internasional dalam mempercepat penelitian dan pengembangan tindakan penanggulangan medis untuk menangani ancaman epidemi dan pandemi di masa depan.
Upaya-upaya itu harus diarahkan melalui peningkatan deteksi, pemantauan, dan respons terhadap wabah penyakit menular. Berikut ini, Medcom.id/gaya merangkum berita menarik yang terjadi sepanjang Selasa, 3 September 2024:
Kepala Pusat Kebijakan Kesehatan Global dan Teknologi Kesehatan Kementerian Kesehatan (Kemenkes) RI Bonanza Perwira Taihitu mengatakan, Indonesia aktif berperan dalam memperkuat sistem kesiapsiagaan global untuk menghadapi ancaman penyakit menular baru, khususnya saat memimpin G20.
Hal ini sejalan dengan upaya kesiapsiagaan di tingkat global dan nasional untuk pencegahan, kesiapsiagaan, dan respons (Prevention, Preparedness and Response/PPR) menghadapi pandemi yang mungkin terjadi kapan saja.
“Pemerintah Indonesia melalui Kementerian Kesehatan RI (Kemenkes) telah melakukan identifikasi patogen prioritas yang berasal dari satwa liar. Proses ini melibatkan para pakar nasional dan internasional termasuk dari WHO, baik di tingkat regional maupun global,” kata Bonanza di Jakarta, ditulis Jumat, 30 Agustus 2024.
Selengkapnya klik di sini
Direktur Pemasaran Pariwisata Nusantara Kementerian Pariwisata dan Ekonomi Kreatif (Kemenparekraf), Dwi Marhen Yono, menjelaskan, salah satu penyebab mahalnya harga tiket pesawat di Indonesia adalah harga avtur yang belum merata. Bahkan lebih mahal daripada negara tetangga.
“Dulu harga avtur di Silangit, Labuan Bajo, dan Jakarta itu beda-beda. Sekarang, Pertamina diwajibkan untuk memberikan harga yang sama di seluruh Indonesia. Harga avtur di Indonesia lebih mahal Rp4.000 per liter dari Singapura, dan lebih mahal Rp7.000 per liter dari Dubai,” ujar Marhen saat penyelenggaraan Astindo Travel Fair akhir pekan lalu.
Kemenparekraf sendiri menargetkan pada tahun ini akan ada 14,3 juta wisatawan mancanegara (Wisman) yang datang ke Indonesia. Artinya terjadi peningkatan pencapaian tahun lalu, yang hanya 11 juta Wisman.
Selengkapnya klik di sini
Mindfulness atau kesadaran penuh menjadi praktik yang populer dalam beberapa tahun terakhir. Bukan tanpa alasan teknik yang melibatkan pemusatan perhatian dapat membantu mengelola stres dan meningkatkan kualitas hidup.
Mindfulness adalah kemampuan dasar manusia untuk secara penuh menyadari apa terjadi terhadap keadaan sekitar dan apa yang dilakukan, dan tidak terlalu reaktif dengan apa yang terjadi di sekitar. Setiap manusia memiliki kemampuan tersebut, tinggal perlu belajar untuk mengakses dan melakukannya.
Berdasarkan kamus Cambridge, mindfulness adalah praktik menyadari tubuh, pikiran, dan perasaan Anda pada saat ini, berpikir untuk menciptakan perasaan tenang.
Selengkapnya klik di sini
Cek Berita dan Artikel yang lain di

(TIN)
Dokumen tersebut menekankan pentingnya kesiapsiagaan, kolaborasi, dan kerja sama internasional dalam mempercepat penelitian dan pengembangan tindakan penanggulangan medis untuk menangani ancaman epidemi dan pandemi di masa depan.
Upaya-upaya itu harus diarahkan melalui peningkatan deteksi, pemantauan, dan respons terhadap wabah penyakit menular. Berikut ini, Medcom.id/gaya merangkum berita menarik yang terjadi sepanjang Selasa, 3 September 2024:
1. WHO Perbaharui Daftar Patogen Global yang Berpotensi Sebabkan Pandemi
Kepala Pusat Kebijakan Kesehatan Global dan Teknologi Kesehatan Kementerian Kesehatan (Kemenkes) RI Bonanza Perwira Taihitu mengatakan, Indonesia aktif berperan dalam memperkuat sistem kesiapsiagaan global untuk menghadapi ancaman penyakit menular baru, khususnya saat memimpin G20.
Hal ini sejalan dengan upaya kesiapsiagaan di tingkat global dan nasional untuk pencegahan, kesiapsiagaan, dan respons (Prevention, Preparedness and Response/PPR) menghadapi pandemi yang mungkin terjadi kapan saja.
“Pemerintah Indonesia melalui Kementerian Kesehatan RI (Kemenkes) telah melakukan identifikasi patogen prioritas yang berasal dari satwa liar. Proses ini melibatkan para pakar nasional dan internasional termasuk dari WHO, baik di tingkat regional maupun global,” kata Bonanza di Jakarta, ditulis Jumat, 30 Agustus 2024.
Selengkapnya klik di sini
2. Tiket Pesawat Masih Mahal, Ini Penjelasan Kemenparekraf
Direktur Pemasaran Pariwisata Nusantara Kementerian Pariwisata dan Ekonomi Kreatif (Kemenparekraf), Dwi Marhen Yono, menjelaskan, salah satu penyebab mahalnya harga tiket pesawat di Indonesia adalah harga avtur yang belum merata. Bahkan lebih mahal daripada negara tetangga.
“Dulu harga avtur di Silangit, Labuan Bajo, dan Jakarta itu beda-beda. Sekarang, Pertamina diwajibkan untuk memberikan harga yang sama di seluruh Indonesia. Harga avtur di Indonesia lebih mahal Rp4.000 per liter dari Singapura, dan lebih mahal Rp7.000 per liter dari Dubai,” ujar Marhen saat penyelenggaraan Astindo Travel Fair akhir pekan lalu.
Kemenparekraf sendiri menargetkan pada tahun ini akan ada 14,3 juta wisatawan mancanegara (Wisman) yang datang ke Indonesia. Artinya terjadi peningkatan pencapaian tahun lalu, yang hanya 11 juta Wisman.
Selengkapnya klik di sini
3. Praktik Mindfulness: Jalan Menuju Ketenangan Batin
Mindfulness atau kesadaran penuh menjadi praktik yang populer dalam beberapa tahun terakhir. Bukan tanpa alasan teknik yang melibatkan pemusatan perhatian dapat membantu mengelola stres dan meningkatkan kualitas hidup.
Mindfulness adalah kemampuan dasar manusia untuk secara penuh menyadari apa terjadi terhadap keadaan sekitar dan apa yang dilakukan, dan tidak terlalu reaktif dengan apa yang terjadi di sekitar. Setiap manusia memiliki kemampuan tersebut, tinggal perlu belajar untuk mengakses dan melakukannya.
Berdasarkan kamus Cambridge, mindfulness adalah praktik menyadari tubuh, pikiran, dan perasaan Anda pada saat ini, berpikir untuk menciptakan perasaan tenang.
Selengkapnya klik di sini
Cek Berita dan Artikel yang lain di
Google News
(TIN)